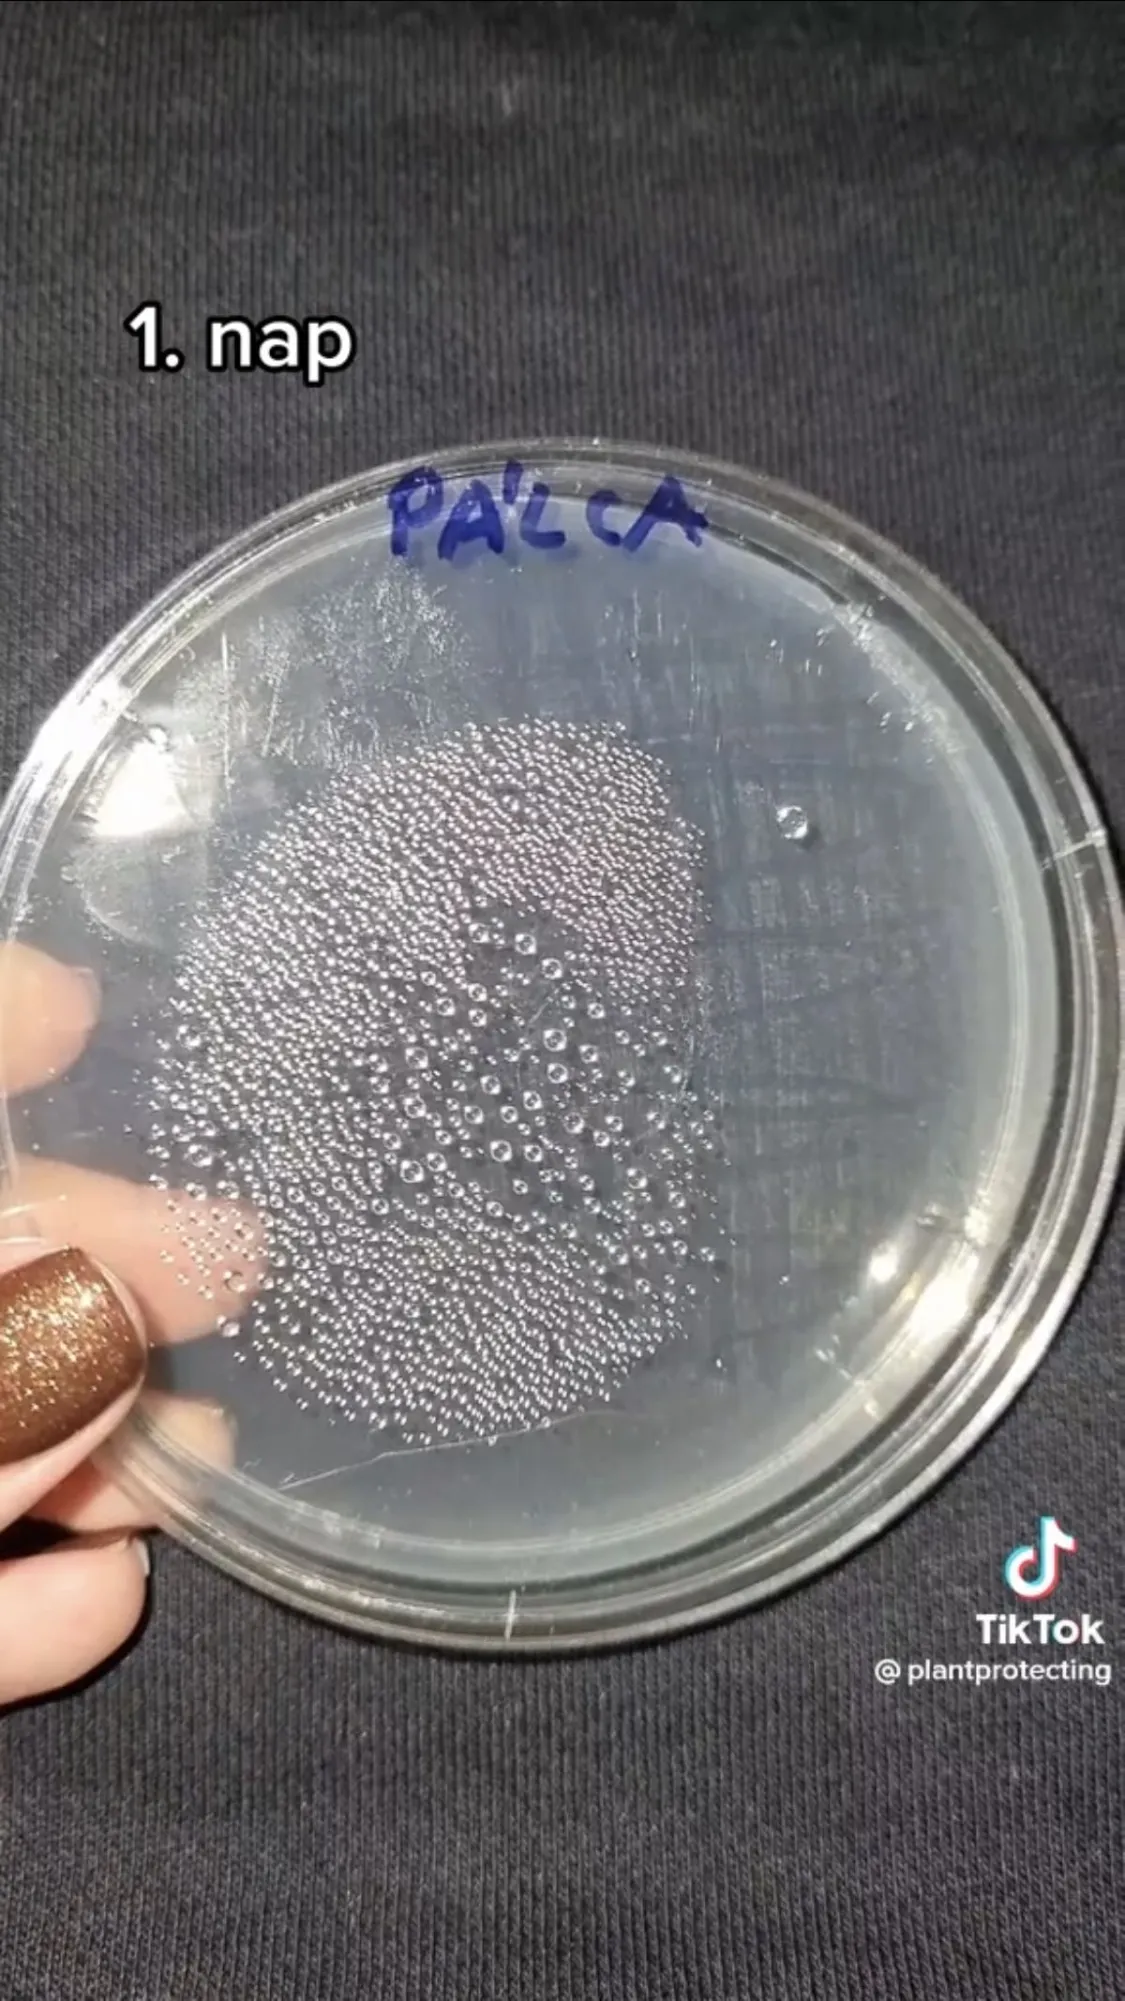
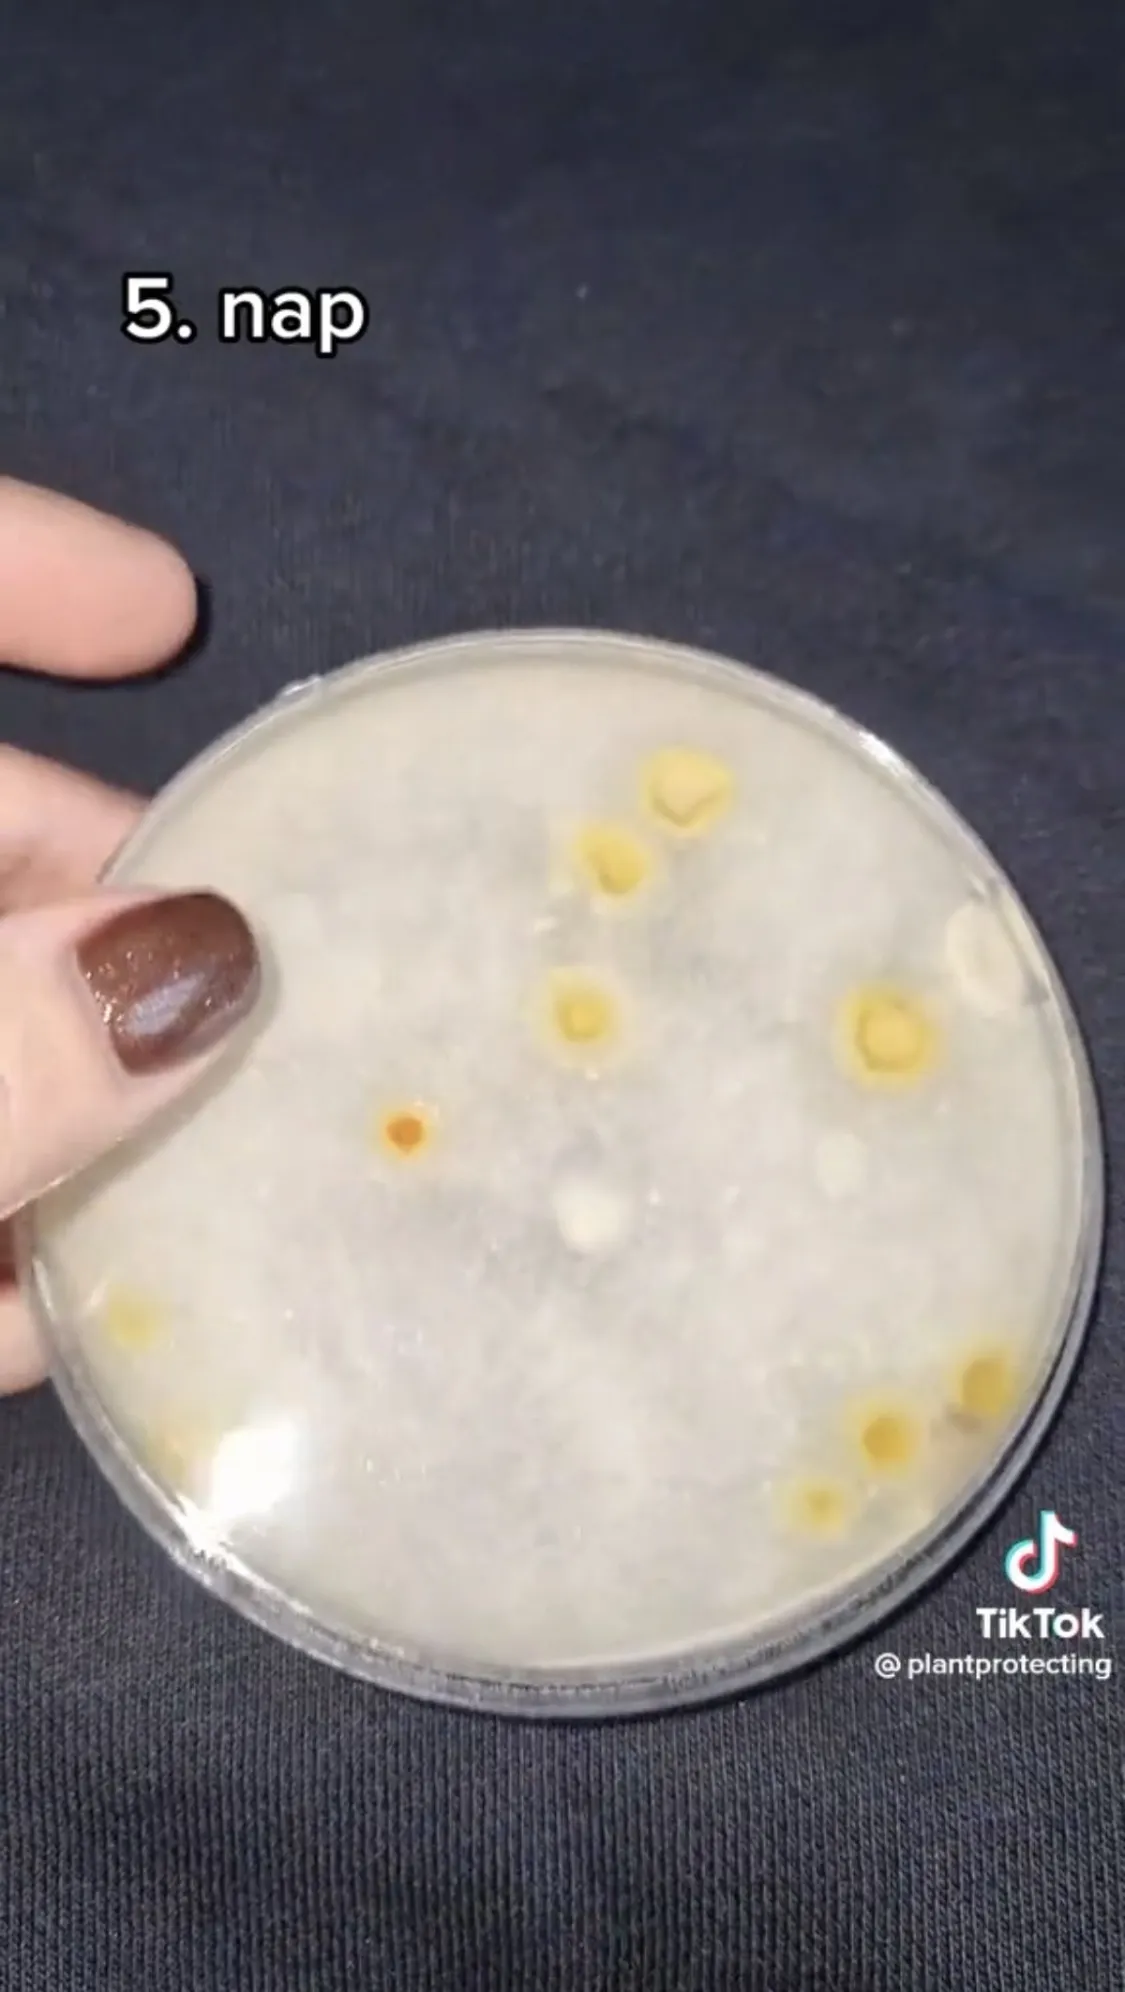

Letesztelte a szakember: ennyi baci van egy hét után a farmerünkön - videó!
Gyuris Rita növényorvos letesztelte, hogy mennyi baktérium és gomba található egy egy hétig hordott farmernadrágon. Mutatjuk az eredményt.
Gyuris Rita növényorvos mindenféle érdekes tárgyról vesz mintát plantprotecting nevű TikTok csatornáján, majd kitenyészti azokat. 130 ezres követőtáborának tesztelt már például villamost, vécét, most pedig egy koszos farmernadrágot is, amelyet egy hétig hordott a teszt előtt.

"Sokkal rosszabbra számítottam"
"Első nap néhány baktériumkolónia és gombatelep jelent meg" - kezdte beszámolóját a piszkos farmernadrágról TikTokker.
A következő napokon szintén nőttek fel újabb baktérium kolóniák és gombatelepek, azonban szerintem semmi durva nincsen rajta. Őszintén én sokkal rosszabbra számítottam, egy hétig hordtam ezt a farmert.
A tömegközlekedés "betehet" a farmereknek is
A videó alatti kommentszekcióban Rita követői megosztották farmerhordási szokásaikat és egyöntetűleg úgy gondolták a teszt előtt, hogy sokkal koszosabb egy napokig viselt farmer, több baktériumot fog találni rajta.
"Pont ez a kérdés volt napokban bennem, mert nem tudok 2-3 napnál többet hordani egy farmert a pesti tömegközlekedés miatt. Köszönöm a videód!" - írta egy követő.
Én is azt hittem, hogy itt aztán minden IS lesz
- jegyezte meg egy másik hozzászóló.
"Én felveszem, elmegyek boltba megy a szennyesbe. Irodában dolgoztam naponta másik nadrág" - osztotta meg egy követő.